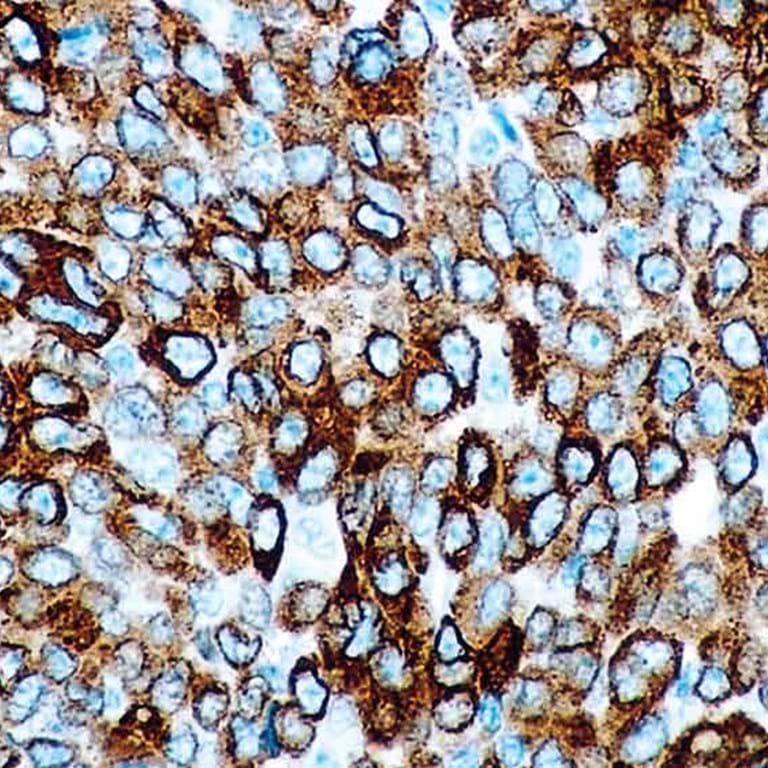

Hardware

Leica BOND-PRIME
Et helautomatisk IHC/ ISH instrument som effektivt takler utfordringer med prøveflyt og kapasitet på laboratoriet.
Forbruksvare
Leica Antistoffer
Leica Biosystems tilbyr antistoffer som gir pålitelig og robust farging innen 14 forskjellige patologiområder.
Forbruksvare

Leica Prober
Leica Biosystems tilbyr et bredt utvalg av prober som er tilgjengelige for både manuell og automatisert bruk.